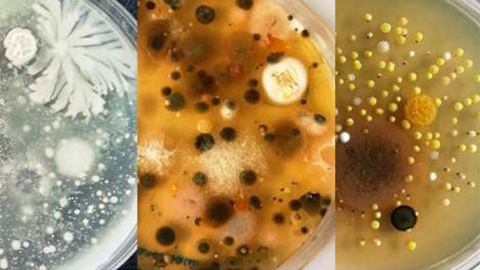
Bacteris Montserrat Llagostera

Trazan el primer mapa de la adaptación y la selección natural de la anatomía completa de un embrión
El grupo de investigación Bioinformática de la Diversidad Genómica de la UAB, en colaboración con el grupo de Biología Evolutiva del Desarrollo de la Universidad de...